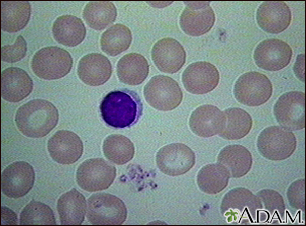
Red blood cells - normal

Red blood cells - normal
Review Date: 10/14/2024
Reviewed By: Warren Brenner, MD, Oncologist, Lynn Cancer Institute, Boca Raton, FL. Review provided by VeriMed Healthcare Network. Also reviewed by David C. Dugdale, MD, Medical Director, Brenda Conaway, Editorial Director, and the A.D.A.M. Editorial team.
The information provided herein should not be used during any medical emergency or for the diagnosis or treatment of any medical condition. A licensed medical professional should be consulted for diagnosis and treatment of any and all medical conditions. Links to other sites are provided for information only -- they do not constitute endorsements of those other sites. No warranty of any kind, either expressed or implied, is made as to the accuracy, reliability, timeliness, or correctness of any translations made by a third-party service of the information provided herein into any other language. © 1997-
A.D.A.M., a business unit of Ebix, Inc. Any duplication or distribution of the information contained herein is strictly prohibited.
A.D.A.M. content is best viewed in IE9 or above, Firefox and Google Chrome browser.
Content is best viewed in IE9 or above, Firefox and Google Chrome browser.

